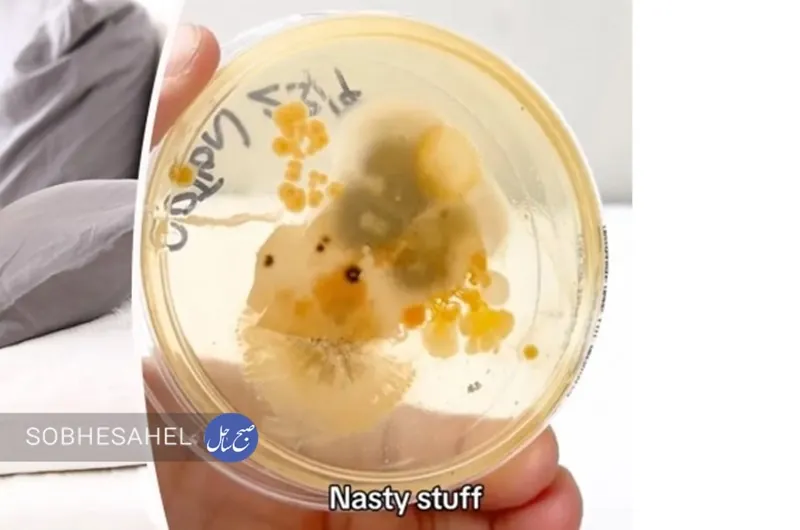
img

سازهای با بزرگترین موزاییک کف در کاپادوکیه و منطقه آناتولی مرکزی در جریان حفاریهای انجامشده در منطقه اورنشهیر واقع در مرکز ترکیه، کشف شد.

نتایج مقاله تحقیقاتی سال ۲۰۲۲ که در نشریه Physics of Fluids منتشر شد، این مورد را مشخص کرد که وضعیت بدن میتواند تا ۸۳ درصد بر میزان جذب دارو تاثیر بگذارد.
09:57 1402/08/07
شما احتمالا در طول زندگی خود بیشتر از هر بیماری دیگری سرما میخورید. بزرگسالان سالانه دو تا سه بار و کودکان خردسال چهار بار یا بیشتر سرما میخورند.
09:49 1402/08/06
فردا، ششم آبان ماه، پس از آنکه ماه کمی از افق بالا آمد، شاهد یک ماه گرفتگی جزیٔی خواهیم بود. در این پدیده سایه زمین روی ماه میافتد و میتوان آن را برای حدود ۷۸ دقیقه در آسمان شهر تماشا کرد.
22:34 1402/08/05
شهردار قشم گفت: تمام امکانات و ظرفیت های موجود برای مقابله با آب گرفتگی معابر عمومی شهر قشم ناشی از بارندگی های پیش رو در آماده باش کامل قرار دارد.
17:32 1402/08/04
مدیرکل حفاظت محیط زیست آذربایجانشرقی از کشف 400 قطعه فسیل 10 میلیون از منطقه آهق مراغه خبر داد.
10:25 1402/08/02
اگرچه راهها و روشهای گوناگونی برای سرقت اطلاعات کاربران و هک گوشی تلفن همراه شناخته و نسبت به آنها هشدار داده شده است، اما اخیرا اعلام شده یکی از روشهای هک کردن دسترسی به اینترنت دیگران از طریق وایفای رایگان است.
11:45 1402/07/28
یک مطالعه جدید نشان داده است که زبان انسان غیر از پنج مزه شامل شیرینی، شوری، تلخی، ترشی و اومامی که تاکنون تعریف شده است، آمونیوم کلرید را نیز به عنوان یک طعم اصلی تشخیص میدهد.
21:31 1402/07/16
کم نیستند افراد بزرگسالی که هنوز هم اگر به طور اتفاقی یک تکه آدامس را قورت بدهند، به سرعت یاد هشدارهای والدینشان در ایام کودکی میافتند که مدام یادآوری میکردند که قورت دادن آدامس، کار خطرناکی است اما آیا واقعا این کار خطرناک و برای سلامتی مضر است؟
19:30 1402/07/15
دانشمندان با توسعه مدلهای مبتنی بر هوش مصنوعی موفق شدند پیشبینی خطر ابتلا به سرطان ریه را سادهتر کنند.
17:57 1402/07/14
اخیرا متخصصان باستانشناسی آلمانی در اهرام ثلاثه مصر، رازهای دیگری از این بنای باستانی کشف کردند. آنها هنگام اجرای یکی از پروژههای بازسازی، به وجود تالارهای جدیدی پی بردند.
13:04 1402/07/14
باستانشناسان حین کاوش در شهر باستانی «آیزانوی» واقع در ترکیه بقایای مواد آرایشی و جواهرات رومی دوهزارساله را کشف کردند.
21:53 1402/07/05
جسد زنجیرشدهای که به تازگی در محوطه یک صومعه باستانی پیدا شده، نه زندانی بوده است و نه اسیر جنگی بلکه راهبی مسیحی بوده که زندگی را با تحمل سختترین ریاضتها به سر میبرده است.
20:55 1402/07/01
باستانشناسان در سواحل مصر در محل معبدی زیر آب در دریای مدیترانه اشیاء و گنجینههای باستانی تازهای را پیدا کردهاند.
17:37 1402/06/29
در کاوش گروه باستانشناسی دانشگاه تهران در قره تپه سگزآباد که به سرپرستی مصطفی دهپهلوان انجام شد، مجموعه تدفین جانوری و انسانی کشف شد. دهپهلوان، سرپرست تیم کاوش قرهتپه، درباره این یافته باستانشناسان دانشگاه تهران، گفت: این مجموعه با مساحت ۵ مترمربع وارتفاع ۱۲۰ سانتیمتر با وزنی حدود ۱۰ تن شامل بقایای ۹ کودک، نوزاد و جنین، بقایای دو اسب بالغ، دو بز و گوسفند است. به دلیل فراهم نبودن شرایط مطلوب در گورستان قرهتپه، این مجموعه کشفشده با رعایت موازین حفاظتی و مرمتی به عنوان یک اثر موزهای برای نمایش و نگهداری به شهرداری شهر سگزآباد انتقال یافت.
11:38 1402/06/23
بخشی از دیوار چین توسط کارگران در مرکز استان شانشی که از بیل مکانیکی برای حفاری استفاده میکردند، به شدت آسیب دیده و تخریب شده است.
19:21 1402/06/14
رئیس پلیس مهاجرت و گذرنامه گفت: اگر در عراق گذرنامه خود را گم کردید یا اینکه گذرنامههایتان مخدوش شد باید حتماً به مراکز کنسولگری ایران در شهرهای مختلف عراق مراجعه کنید.
14:57 1402/06/11
بدن انسان به انواع ویتامینها و مواد مغذی نیاز دارد تا بتواند عملکرد بهتری داشته باشد. گاهی می توانید با جایگزینی خوراکیهای ارزانقیمت اما مفید به جبران این کمبودها بپردازید.
08:47 1402/06/08
پزشکان در استرالیا توانستند با انجام عمل جراحی یک کرم لولهای زنده به طول ۸ سانتیمتر را از مغز یک بیمار خارج کنند.
20:13 1402/06/07
ابرماه زمانی اتفاق میافتد که ماه کامل به نزدیکترین نقطه به زمین در مدارش نزدیک شود. مدار ماه به دور زمین بیضوی است، بنابراین هر ماه به نزدیکترین نقطه (حضیض) و دورترین نقطه (اوج) می رسد.
13:12 1402/06/06
همزمان با نزدیک شدن اربعین حسینی و برگزاری مراسم پیاده روی، حالا برای بسیاری از عاشقان زیارت کربلای معلی این سئوال مطرح است که:
20:37 1402/06/04
دانشمندان در پژوهش جدیدی نتیجه گرفتهاند که شبکاری میتواند ریسک ازدستدادن حافظه در میانسالی و سالمندی را افزایش دهد.
18:38 1402/06/04
باغ وحش برایتس در ایالت تنسی بعد از تولد یک بچه زرافه و پی بردن به نادر بودن این حیوان، از آن رونمایی کرد.
19:33 1402/05/31
دانشمندان میگویند این گونه «فسیل زنده» بیش از ۲۰۰ میلیون سال است که در اقیانوسهای سطح زمین زیست میکند.
17:43 1402/05/28
زائران پیاده روی اربعین حتما در نوشیدن آب باید نکاتی را رعایت کنند تا سلامت آنها حفظ شود.
20:41 1402/05/21
دانشمندان در مطالعه جدیدی دریافتهاند که اولین زنبورها بالغ بر 120 میلیون سال پیش پدید آمدند، اما سرعت تکثیر و افزایش تنوع آنها خیلی سریعتر از انتظارات قبلی ما بوده است. این موجودات از انقراض دایناسورها جان سالم به در بردند، اما حالا در عصر حیات انسانها با تهدیدی جدی روبهرو شدهاند.
18:43 1402/05/13
دو ابرماه از جمله یک ماه آبی کمیاب آسمان را در ماه آگوست روشن میکنند و این منظره تا ۱۴ سال دیگر دیده نخواهد شد. ابرماه زمانی اتفاق میافتد که ماه در نزدیکترین نقطه به زمین و در عین حال ماه کامل باشد.
14:27 1402/05/10
در یک روز گرم تابستان، عطش خود را با نوشیدن یک لیوان آب خنک فرو مینشانید یا جلوی کولر مینشینید. اما چگونه وسایل الکترونیکی خود را از گرما نجات میدهید؟
21:32 1402/05/09
کارشناسان به هزاران نفر از دارندگان اندروید و آیفون هشدار دادهاند که هرگز مرتکب ۵ اشتباه در زمان شارژ باتری نشوند.
18:33 1402/05/07
دانشمندان آب اقیانوسی ۶۰۰ میلیون ساله را در ذخایر معدنی هیمالیا کشف کردند.
15:32 1402/05/07
آیفون از جمله گرانقیمتترین گوشیهای هوشمند موجود در بازار است که احتمالاً فقط عده خاصی از افراد قادر به خرید نسخههای جدید آن هستند. حالا در یک خبر عجیب گفته شده که زوجی در ایالت «بنگال غربی» هند، فرزند شیرخوار خود را برای خرید یک آیفون 14 و ساخت ریلزهای اینستاگرام فروختهاند.
18:08 1402/05/06
جسد یک کوهنورد آلمانی که نزدیک به ۴ دهه قبل در معروفترین رشته کوه اروپا مفقود شده بود، شناسایی شد.
14:01 1402/05/06
بسیاری از افراد بر اساس یک باور قدیمی، اگر سهوا یا عمدا خربزه و عسل را با هم مصرف کنند، نگران و مضطرب میشوند.
12:11 1402/05/03
امشب ماه، میزبان تعدادی از سیاره های منظومه شمسی و ستاره ای از صورت فلکی شیر بزرگ است و از غروب میتوانیم شاهد همنشینی آن با زهره، مریخ، تیر و ستاره قلبالاسد در آسمان این شب گرم تابستانی باشیم.
17:50 1402/04/29
در این مقاله قصد داریم به معرفی اضطراب و مفاهیم مرتبط با آنها بپردازیم، پس تا پایان با ما همراه باشید.
21:35 1402/04/26
باستانشناسان مقبرههای متعلق به عصر برنز را کشف کردهاند که مملو از طلا و سنگهای قیمتی است و میتوان آنها را در زمره برخی از غنیترین مقبرههای کشفشده در مدیترانه قرار داد.
19:34 1402/04/25
باستانشناسان با کاوش در کشور «پرو» یک دالان مُهر و مومشده چند هزارساله را کشف کردند.
18:10 1402/04/23
هماکنون بیش از هشت میلیارد نفر در زمین زندگی میکنند. ولی اگر به یکباره تمام انسانها از روی سیاره ما حذف میشدند، چه اتفاقی میافتد؟
11:58 1402/04/23
عضو هیئت علمی پژوهشکده گیاهان دارویی جهاددانشگاهی، گیاهان دارویی موثر بر مشکل عرق کردن زیاد را تشریح کرد.
16:21 1402/04/22
فصل گرما که فرا میرسد همه به دنبال نوشیدنیهایی برای کم کردن عطش خود هستند، اما میتوان به جای نوشابههای مضر، از نوشیدنیهای خنک سنتی استفاده کرد.
19:58 1402/04/18
ژاپنی ها میوه جدیدی تولید کرده اند که خربزه لیمو است!
21:34 1402/04/15
وقتی یک نهنگ عنبر در ساحل جزیره «لاپالما» در مجمع الجزایر قناری اسپانیا مرده پیدا شد، هیچ کس تصور نمیکرد که گنج ارزشمندی در رودههایش پنهان باشد.
22:39 1402/04/14
میانگین دمای جهان روز دوشنبه گذشته مصادف با تاریخ سوم ژوئیه با عبور از ۱۷ درجه سانتیگراد رکورد جدید را ثبت کرده است.
11:31 1402/04/14
تعداد فنجان زیاد از این نوشیدنی برای سلامتی شما مضر است و خطر بیماری قلبی را یک چهارم افزایش میدهد.
10:55 1402/04/12
یک عدد روبالشی تنها 7 روز پس از شست وشو میتواند میزبان 3 میلیون باکتری باشد. این رقم حدود ۱۷ هزار برابر بیشتر از میانگین باکتری است که روی صندلی توالت فرنگی وجود دارد.
18:47 1402/04/11
یک کیف دستی مینیاتوری که در نوک انگشت دست جا میشود در یک حراج آنلاین به قیمت بیش از ۶۳ هزار دلار فروخته شد.
18:42 1402/04/09
در مطلب زیر ماشین های کارکرده همقیمت با پژو ۲۰۷ اتوماتیک در خارج کشور معرفی خواهند شد.
20:29 1402/04/06آخرین اخبار

استخدام حسابدار با هفت سال سابقه کار در یک شرکت معتبر

نخستین پیام بنزما پس از پیوستنش به الهلال

جنگلهای ساحلی سپر سبز هرمزگان در برابر ریزگرد و سیلاب هستند

خودروی جدید تسلا معرفی شد

الناز شاکردوست از سینمای ایران خداحافظی کرد؟
پربازدیدترین ها

یک شرکت معتبر و فعال در حوزه کاری خود، بهمنظور تکمیل کادر مالی، از میان متقاضیان واجد شرایط اقدام به جذب حسابدار با حداقل هفت سال سابقه کاری میکند.

کاپیتان فرانسوی الاتحاد بعد از جدایی از این تیم و پیوستن به الهلال پیامی را برای هواداران تیم سابقش منتشر کرد.

مدیرکل منابع طبیعی هرمزگان گفت: جنگلهای ساحلی و مانگرو بهعنوان یکی از مهمترین سرمایههای طبیعی کشور، نقشی حیاتی در کنترل ریزگردها، کاهش خسارات سیلاب، حفاظت از سواحل دارند.

تسلا یک نسخه جدید از خودروی پرفروش «مدل وای» را در آمریکا با قیمت ۴۱ هزار و ۹۹۰ دلار معرفی کرد.

الناز شاکردوست بازیگر سرشناس سینما و دارنده سیمرغ بلورین جشنواره فیلم فجر با انتشار متنی گلایه آمیز از حوادث اخیر، رسماً کناره گیری اش از سینمای ایران را اعلام کرد.